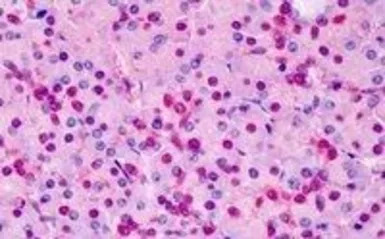
Triosephosphate isomerase anti

相关产品推荐更多 >
万千商家帮你免费找货
0 人在求购买到急需产品
- 详细信息
- 文献和实验
- 技术资料
- 免疫原:
Peptide with sequence C-LKPEFVDIINAKQ, from the C Terminus of the protein sequence according to NP_000356.1; NP_001152759.1.
- 亚型:
IgG
- 形态:
Liquid
- 保存条件:
Store as concentrated solution. Centrifuge briefly prior to opening vial. For short-term storage (1-2 weeks), store at 4ºC. For long-term storage, aliquot and store at -20ºC or below. Avoid multiple freeze-thaw cycles.
- 克隆性:
Polyclonal
- 标记物:
Unconjugated
- 适应物种:
Human, Mouse
- 保质期:
12 months from the shipping date of the product.
- 抗原来源:
Human
- 目录编号:
GTX89594
- 级别:
Primary Antibodies
- 库存:
Available
- 供应商:
GeneTex
- 宿主:
Goat
- 应用范围:
WB, IHC-P
- 浓度:
0.50 mg/ml (Please refer to the vial label for the specific concentration.)
- 靶点:
This antibody is expected to recognise reported isoforms 1 and 2 (NP_000356.1; NP_001152759.1).
- 抗体英文名:
Triosephosphate isomerase antibody, C-term
- 抗体名:
Triosephosphate isomerase 抗体, C-term
- 规格:
100 μg
IHC-P analysis of human pancreas using GTX89594 Triosephosphate isomerase antibody, C-term.
Antigen retrieval : Tris/EDTA buffer pH 9
Dilution : 5μg/ml

WB analysis of human liver lysate using GTX89594 Triosephosphate isomerase antibody, C-term.
Dilution : 0.003μg/ml
Loading : 30μg protein in RIPA buffer

IHC-P analysis of human liver using GTX89594 Triosephosphate isomerase antibody, C-term.
Antigen retrieval : Tris/EDTA buffer pH 9
Dilution : 2μg/ml
风险提示:丁香通仅作为第三方平台,为商家信息发布提供平台空间。用户咨询产品时请注意保护个人信息及财产安全,合理判断,谨慎选购商品,商家和用户对交易行为负责。对于医疗器械类产品,请先查证核实企业经营资质和医疗器械产品注册证情况。
 文献和实验
文献和实验于研究。 性能参数 LIST OF ANTBODY PRODUCTS AP8401a BDP1 N-term Antibody AP8408b MEG2 C-term Antibody AP8451b PPP3CA C-term Antibody AP8449b CTDSP1 C-term Antibody AP8408a MEG2 N-term Antibody AP8451a PPP3CA N-term Antibody AP8449
Identifying Functional Sites Based on Prediction of Charged Group Behavior
(solid circles), and H248 (hollow triangles) in one of the two subunits of the triosephosphate isomerase (TIM) dimer. View Image
【资源】全面归类网址:毕赤酵母表达各种来源蛋白(细菌,真菌,植物,人类等)
europaea (olive tree) aeroallergen Ole e 1S, 60 mg/L, α-MF[115, 334, 391]Olea europaea 1,3-β-glucanase Ole e 9 C-term.seg.S, 100 mg/L, α-MF, active486Oleaceae sp. (lilac and privet) pollen allergensS, 30 mg/L, reactive481Pepper endo-b-1,4-glucanase cCel1S
 技术资料
技术资料暂无技术资料 索取技术资料





![IL6 antibody [1B1-B10-D2]](https://img1.dxycdn.com/2022/0328/464/3689739767827300453-14.jpg!wh200)





